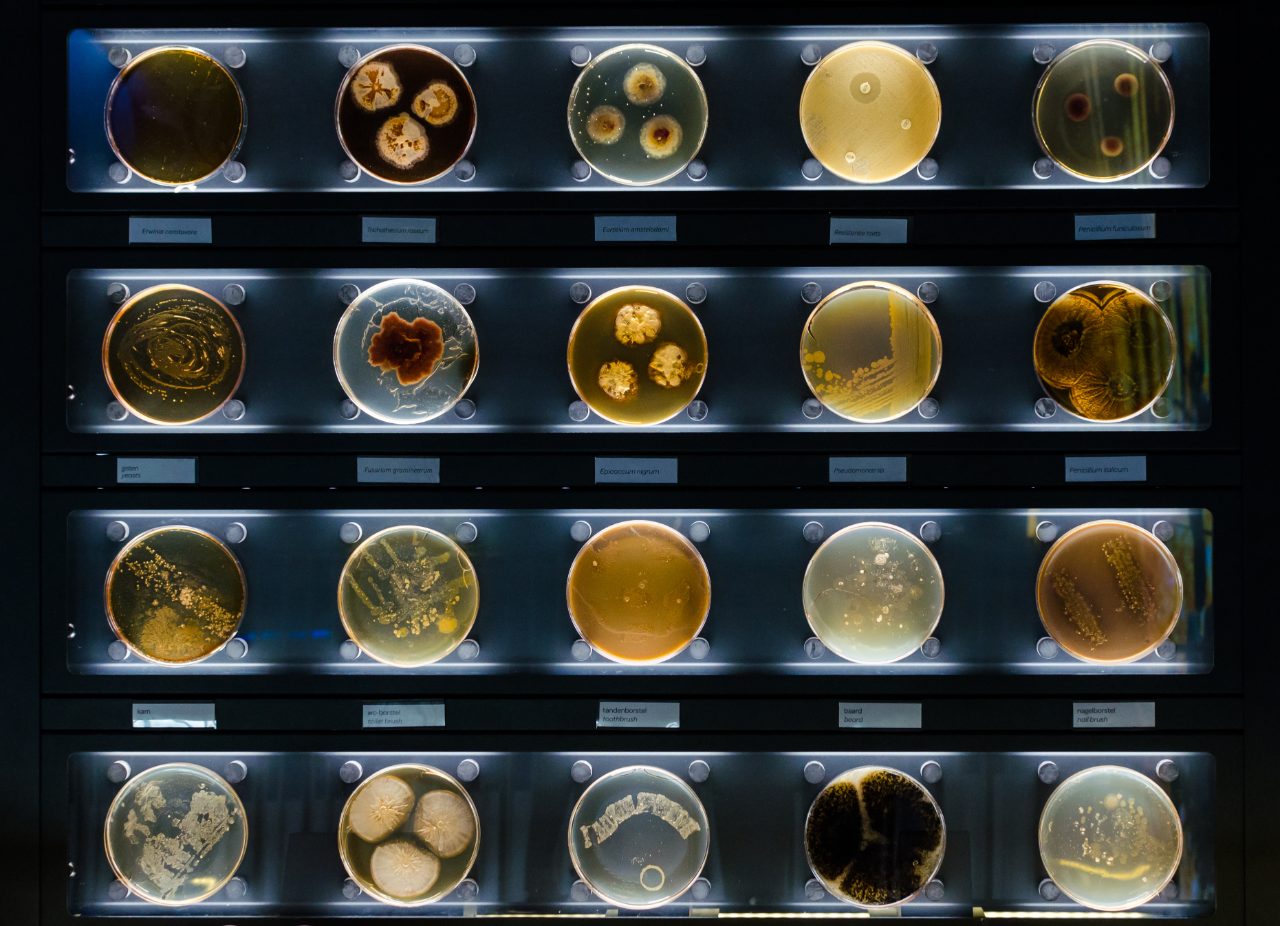
shutterstock1416813431-maldi-biotyper-microbial-research-bruker-md-web

Food & Beverage Microbiology
Food Microbiology
Accurate microbiological testing technology is vital for the detection of foodborne pathogens, possible food spoilage organisms and technological strains. Rapid identification/confirmation and strain typing methods enable food and beverage manufacturers to make fast quality and safety decisions.
MALDI Biotyper® and IR Biotyper® - A seamless solution for microorganism confirmation/identification and strain typing in food microbiology
Only one well-equipped benchtop furnished with the dedicated MALDI Biotyper® solution for food microbiology, complemented by the IR Biotyper®, is needed for confirmation/identification and strain typing of microorganisms in less than 3 hours.
The MALDI Biotyper® provides specific and reliable identification of microorganisms within minutes. The system has been validated and certified according to the Official Method of Analysis program (OMA) of the AOAC International and according to the new ISO 16140-part 6 standard.
The IR Biotyper® allows for easy, fast and cost-effective microbial typing for real-time quality control and source tracking.
Food quality
Rapid and reliable identification of positive microflora and microbial contaminants during hygiene and quality controls is crucial. In addition to confirming the absence of unexpected microbial contaminants, food manufacturers must prevent microbial spoiler growth during food formulation, production and storage.
Fingerprinting of technological strains is required to assure that the product intermediates and the final formulation meet predefined quality and functional properties.
Food safety
Fast confirmation of foodborne pathogens and quality indicators are critical for manufacturers to make timely decisions, such as in the case of food batch withdrawal. Real-time confirmation and identification results for Salmonella spp., Cronobacter spp., Campylobacter spp., Listeria spp. and Listeria monocytogenes from a range of agar plates confers critical time savings, by testing multiple colonies in one run.
Proper monitoring of contaminations by fingerprinting of the microbial isolates facilitates proactive root cause analyses and corrective actions in the cleaning process management.
Insights from Dr. Francis Muchaamba
Looking for more insights? Discover how FT-IR spectroscopy helped uncover the truth!
Not for use in clinical diagnostic procedures.
Please contact your local representative for availability in your country.